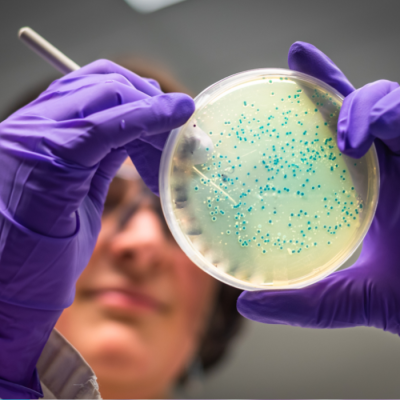

''Santa Monica'' integrative medical clinic services include:
Cancer Treatment and Therapies:
-
Whole-body hyperthermia
-
Local hyperthermia
-
Biological infusions
-
Intravenous infusions and injections
-
Immune system strengthening therapies
-
Palliative care
Diagnostics:
-
Cancer cell analysis
-
Heavy metal testing
-
Microbiome testing
Rehabilitation and Post-Treatment Support:
-
Rehabilitation after chemotherapy
-
Individualized rehabilitation programs
-
Shockwave therapy and pain management
-
LPG massage
-
Infrared sauna
-
Nutritional therapy and detoxification
Consultations and Lifestyle Optimization:
-
Personalized cancer treatment consultations
-
Supplement and nutrition counseling
-
Support for chronic pain and autoimmune conditions
Santa Monica Clinic offers a comprehensive approach, combining traditional and integrative medicine to enhance patient health, strengthen the body’s self-healing mechanisms, and improve quality of life during and after treatment.
.png)

.jpg)
.jpg)


.jpg)




